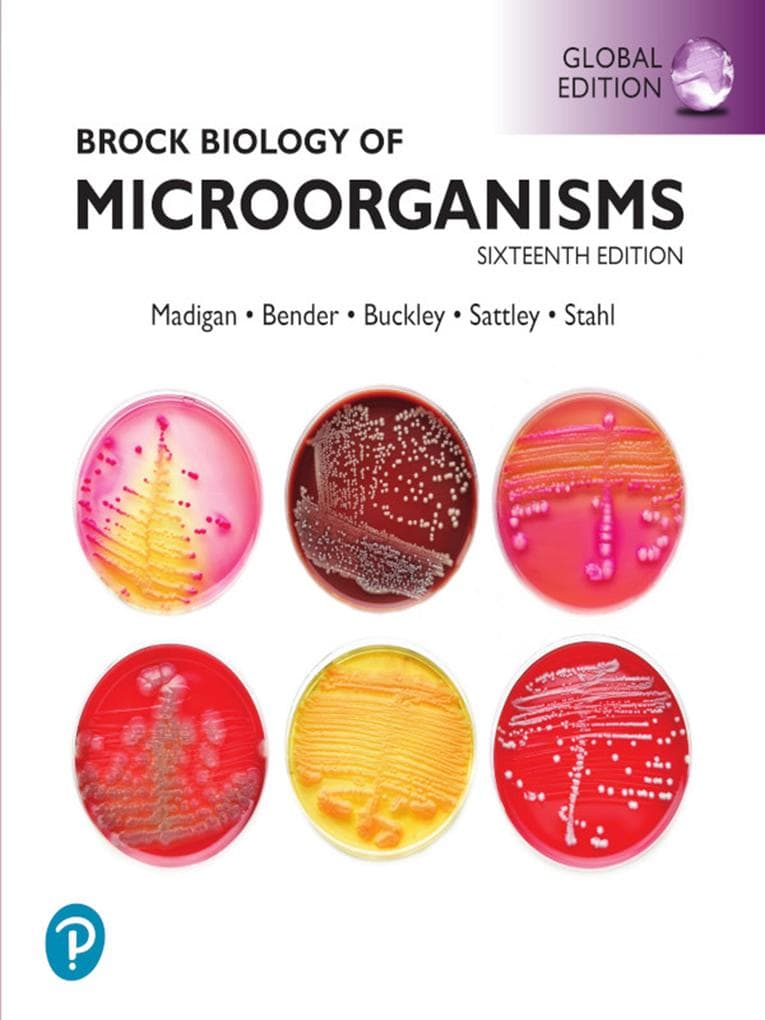
Brock Biology of Microorganisms, Global Edition

353.313 Treffer
eBook pdf
Sprache: Englisch Sofort lieferbar (Download)
20,99 €*
Ein weiteres Format
Using Microsoft Dynamics 365 for Finance and Operations: Learn and understand the Dynamics 365 Supply Chain Management and Finance apps
Andreas LuszczakeBook pdf
Sprache: Englisch Sofort lieferbar (Download)
47,99 €*
eLearning and Mobile Learning - Concept and Script: Handbook for Media Authors and Project Managers
Daniela ModlingereBook pdf
Sprache: Englisch Sofort lieferbar (Download)
69,49 €*
Ein weiteres Format
eBook pdf
Sprache: Englisch Sofort lieferbar (Download)
3,99 €*